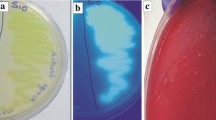

Abstract
Of 80 fluorescent pseudomonad strains screened for phosphate solubilization, three strains (BFPB9, FP12 and FP13) showed the ability to solubilize tri-calcium phosphate (Ca3(PO4)2). During mineral phosphate solubilization, decrease of pH in the culture medium due to the production of organic acids by the strains was observed. These phosphate solubilizing strains produced indole-3-acetic acid (IAA) and protease as well as exhibited a broad-spectrum antifungal activity against phytopathogenic fungi. When tested in PCR using the gene-specific primers, strain BFPB9 showed the presence of hcnBC genes that encode hydrogen cyanide. On the basis of phenotypic traits, 16S rRNA sequence homology and subsequent phylogenetic analysis, strains BFPB9, FP12 and FP13 were designated as Pseudomonas aeruginosa, P. plecoglossicida and P. mosselii, respectively. Present investigation reports the phosphate solubilization potential and biocontrol ability of new strains that belong to P. plecoglossicida and P. mosselii. Because of the innate potential of phosphate solubilization, production of siderophore, IAA, protease, cellulase and HCN strains reported in this study can be used as biofertilizers as well as biocontrol agents.
Similar content being viewed by others
Avoid common mistakes on your manuscript.
Introduction
Fluorescent pseudomonads, the group of Gram negative, motile rods distributed in temperate as well as in tropical soils are predominate among bacteria associated with plant rhizospheres (Glick 1995; Sakthivel and Gnanamanickam 1989; Sutra et al. 2001). These bacteria that inhabit different geographical regions produce an array of enzymes and metabolites of biotechnological importance such as enzymes involved in solubilizing of inorganic phosphate and iron, vitamins, phytohormones and antimicrobial metabolites and also capable of improving plant nutrients uptake, tolerance to stress, salinity, metal toxicity and pesticide (O’Sullivan and O’Gara 1992; Vassilev et al. 2006).
Phosphate solubilizing bacteria have been reported for promoting plant growth and enhancing yield (Kapoor et al. 1989; Rodriguez and Fraga 1999). Secretion of organic acids and phosphatase enzymes are common mechanisms that facilitate the conversion of insoluble forms of phosphorous to plant available forms (Kim et al. 1998; Richardson 2001). Solubilization of insoluble phosphorous to accessible forms like orthophosphate is one of the important traits of plant growth promoting rhizobacteria (PGPR). The PGPR producing IAA hormone are known to have dual role in influencing plant growth, by involving in the biocontrol together with glutathione-s-transferases in defence-related plant reactions and inhibit the germination of spore and growth of mycelium of different pathogenic fungi (Brown and Hamilton 1993). IAA hormone when supplied to excised potato leaves eventually reduced the severity of the disease provoked by Phytophthora infestans (Martinez Noel et al. 2001). Pathogen-suppressing ability of fluorescent pseudomonads is mainly due to their potential to produce an array of antibiotics viz., phenazines (Gurusiddaiah et al. 1986; Pierson and Thomashow 1992), pyrrole-type compounds (Homma and Suzui 1989; Pfender et al. 1993), polyketides (Kraus and Loper 1995) and peptides (Nielsen et al. 1999, 2000; Sorensen et al. 2001).
Fluorescent pseudomonads being major group of rhizobacteria colonise aggressively with the plant roots have been considered as an important group for sustainable agriculture and therefore, the screening of such bacteria with biofertilizing and biocontrol properties has been the subject of interest. Fluorescent pseudomonad species such as P. chlororaphis, P. putida, P. aeruginosa, P. fluorescens, P. trivialis, P. striata and P. poae have been identified as phosphate solubilizing rhizobacteria (Cattelan et al. 1999; Gaind and Gaur 2002; Bano and Musarrat 2003; Sunish Kumar et al. 2005; Gulati et al. 2008). Present study was aimed to isolate phosphate solubilizing fluorescent pseudomonad strains and to study their functional characteristics for plant growth and biocontrol of phytopathogens.
Materials and methods
Isolation and screening of phosphate solubilizing fluorescent pseudomonads
Rhizosphere soil samples were collected from the rice field located at Puducherry. Soil suspensions were obtained by shaking 10 g of tightly adhering soil on roots in 90 ml of 0.1 M MgSO4 · 7H2O buffer for 10 min at 180 rpm in a rotary shaker. Serial dilutions of the rhizospheric soils (100 μl) were plated onto Pseudomonas isolation agar (Difco Laboratories, Detroit, USA) and incubated for 2 days at 28°C. Pure cultures were established from single colonies. Colonies were streaked onto King’s B agar (per litre contains 20 g protease peptone, 15 ml glycerol, 1.5 g K2HPO4, 1.5 g MgSO4 · 7H2O and 15 g agar, pH 7.0) (King et al. 1954). After 2 days incubation at 27°C, colonies were screened for fluorescence under UV light (366 nm). To determine the solubilisation of phosphate, strains were streaked onto Pikovskaya’s agar medium (Pikovskaya 1948). After 3 days of incubation at 28°C, bacteria that induced clear zone around the colonies were considerd positive.
Time courses of growth and estimation of soluble phosphates
Strains were inoculated to 50 ml of phosphate solubilization estimation medium (per litre contains 0.5 g yeast extract, 10 g dextrose, 5 g CaCl2, 0.5 g (NH4)2SO4, 5 g Ca3(PO4)2, 0.2 g KCl, 0.1 g MgSO4, 0.0001 g MnSO4 and 0.0001 g FeSO4, pH 7.0) and grown at 28°C with 180 rpm on rotary shaker. At different time intervals (1, 3, 5, 7 and 10 days), samples were drawn and used for the estimation of soluble phosphate and for checking the pH of the culture medium. For estimation of soluble phosphate in culture medium, 1 ml culture filtrate was added to 4.5 ml of chloromolybdic acid (1.5 g of ammonium molybdate was dissolved in 40 ml of warm water, 34.2 ml of 12N HCl was added, allowed to cool and made up to 100 ml with distilled water) in each test tube and vortexed. To this 0.025 ml of chlorostannous acid (2.5 g of SnCl2 · H2O dissolved in 10 ml of 12N HCl, made up to 100 ml with distilled water) was added and immediately made volume to 5 ml. Optical density (OD) was measured at 600 nm. Standard curve was prepared using 50, 100, 150, 200, 250 and 300 μg ml−1 concentrations of potassium dihydrogen phosphate.
Siderophore assay
Production of siderophore was determined using chrome azurol S (CAS) agar method (Alexander and Zuberer 1991). Briefly, the bacterial inoculum was dropped onto the centre of a CAS plate. After incubation at 28°C for 5 days, siderophore production was assessed by change in the colour of the medium from blue to orange.
Determination of indole-3-acetic acid (IAA)
The production of IAA was determined using LB-tryptophan agar (Bric et al. 1991). Single colony was streaked onto LB agar amended with 5 mM l-tryptophan, 0.06% sodium dodecyl sulphate and 1% glycerol. Plates were overlaid with Whatman no. 1 filter paper (82 mm diameter) and the bacteria were allowed to grow for a period of 3 days. After the incubation period, the paper was removed and treated with Salkowski’s reagent (Gordon and Weber 1951) with the formulation of 2% ferric chloride (0.5 M) in 35% perchloric acid. Membranes were saturated in a Petri dish by soaking directly in Salkowski’s reagent and the production of IAA was identified by the formation of a characteristic red halo within the membrane immediately surrounding the colony.
Determination of protease
Protease production was determined using skim milk agar (per litre contains 5 g pancreatic digest of casein, 2.5 g yeast extract, 1.0 g glucose, 100 ml of 7% skim milk solution and 15 g agar). Bacterial cells were spot inoculated and incubated for 2 days at 28°C. Proteolytic activities were identified by clear zone around the cells (Smibert and Krieg 1994).
Determination of cellulase
Production of cellulase was determined using carboxymethyl cellulose (CMC) agar method (Cattelan et al. 1999). Bacteria were spot inoculated onto M9 medium agar amended with 10 g of carboxymethyl cellulose, 1.2 g of yeast extract, congo red (0.02%) per litre of distilled water. After 8 days of incubation at 28°C, colonies surrounded by clear halos were considered positive for cellulase production.
Test for antagonism
Fungal pathogens, Rhizoctonia solani RSR1 (sheath blight of rice), Magnaporthe grisea MGS (blast of rice), Macrophomina phaseolina MPS (charcoal rot of ground nut), Sarocladium oryzae SONS (sheath rot of rice), Botrytis cinerea BCTNAU (Blight of tobacco), Pestalotia theae PTS (leaf spot of tea), Colletotrichum falcatum (red rot of sugarcane), C. capsici CPS (fruit rot of chilli) and C. gleosporoides CGS (anthracnose of mango), Fusarium oxysporum f. sp. cubense FOC (discoloration of banana), F. oxysporum f. sp. vasinfectum FOVS (wilt of cotton), Cylindrocladium floridanum ATCC42971 (root necrosis of banana) and Cy. scoparium ATCC46300 (root necrosis of banana) were used in this study. Strains were tested for in vitro antagonism towards fungal pathogens by following standard co-inoculation technique on potato dextrose agar (Sakthivel and Gnanamanickam 1987; Ayyadurai et al. 2007). Briefly, bacterial plugs (6 mm diameter) were removed from a 48 h culture and were transferred to the centre of PDA plates, which had been inoculated with fungal spore suspension (106 conidia ml−1). Assay plates were incubated at 28°C for 3 days and growth-inhibition appeared around the bacterial plugs was measured.
Detection of antibiotic genes and production of antifungal metabolites
Total genomic DNA was extracted using the method as described earlier (Sakthivel et al. 2001). Detection of the genes that encode for the production of antibiotics such as, 2,4-diacetylphloroglucinol (DAPG), phenazine-1-carboxylic acid (PCA), phenazine-1-carboxamide (PCN), pyrrolnitrin (PRN), pyoluteorin (PLT) and hydrogen cyanide (hcnBC) was done by PCR using gene-specific primers. Reference strains, Pseudomonas fluorescens Pf5, P. fluorescens 2–79, P. aureofaciens 30–84, P. aeruginosa PAO1 were used as positive controls for the detection of antibiotic gene. Oligonucleotide primers were synthesised by Integrated DNA Technologies Inc. (Coralville, IA, USA). Details of sequences of primer pairs, Phl2a–Phl2b for DAPG, PCA2a–PCA3b for PCA, PhzHup–PhzHlow for PCN, Prncf–Prncr for PRN, PltBf–PltBr for PLT, ACa–ACb for hcnBC and amplification conditions are given in Table 1. PCR reaction (50 μl) contained 50 pmol of primer, 50 ng of genomic DNA, 1× Taq DNA polymerase buffer, 0.5 U of Taq DNA polymerase (Promega, Madison, WI, USA), 0.2 mM of each deoxynucleotide triphosphate, and 1.5 mM MgCl2. Amplification was performed in a DNA thermal cycler (Mastercycler epgradient PCR machine, Eppendorf, Germany). A 5 μl aliquot of each amplification product was electrophoresed on a 0.7% agarose gel in 1× Tris–acetate–EDTA (TAE) buffer at 50 V for 45 min, stained with ethidium bromide, and the PCR products were visualised under UV transilluminator and documented in Gel documentation system (Vilber Lourmat, France). In order to test the production of antifungal metabolites, strains were inoculated in the fermentation media. Production of DAPG and PCA was tested by growing bacteria in pigment producing medium (per litre contains 20 g peptone, 20 ml glycerol, 5 g NaCl and 1 g KNO3, pH 7.2) for 5 days at 28°C (Gurusiddaiah et al. 1986). Production of PLT was tested by growing bacteria in KB broth for 14 days at 25°C (de Souza and Raaijimakers 2003). PRN production was tested by growing bacteria in a minimal medium (per litre contains 30 g glycerol, 3 g K2HPO4, 0.5 g KH2PO4, 5 g NaCl, 0.5 g MgSO4 · 7H2O, 0.35 mM ZnSO4, 0.5 mM MO7(NH4)6O24 · H2O and 0.61 g d-tryptophan) for 24 h at 25°C and subsequently incubated at 25°C in a dark for 4 days (de Souza and Raaijimakers 2003). The culture supernatants were extracted with ethyl acetate and the production of antibiotics was verified by analytical HPLC as described (Ayyadurai et al. 2007).
Production of hydrogen cyanide (HCN)
To determine the production of HCN, bacteria were streaked onto KB agar plates supplemented with glycine (4.4 g l−1). After this, the Petri dish was inverted and a piece of filter paper impregnated with 0.5% picric acid (yellow) and 2% sodium carbonate was placed on the lid. Petri dish was sealed with parafilm and incubated at 28°C for 96 h. Discoloration of the filter paper from orange to brown after incubation was considered as microbial production of cyanide (de Souza and Raaijmakers 2003; Sunish kumar et al. 2005).
16S rRNA gene amplification, sequencing and phylogenetic tree analysis
Amplification of 16S rRNA gene was performed from the genomic DNA of bacteria as described earlier using universal primers fD1 (5′-GAGTTTGATCCTGGCTCA-3′) and rP2 (5′-CGGCTACCT TGTTACGACTT-3′) (Weisburg et al. 1991). PCR cocktail (50 μl) contained 50 pM of primer, 50 ng of genomic DNA, 1× Taq DNA polymerase buffer, 1 U of Taq DNA polymerase (Promega, Madison, WI, USA), 0.2 mM of each dNTP, and 1.5 mM MgCl2. Amplification was performed in PCR machine (Perkin Elmer 2400, USA) programmed with an initial denaturation at 94°C for 3 min, followed by 30 cycles of 10 s at 94°C, 1 min at 56°C and 30 s at 72°C with an extension of 72°C for 5 min. A 5 μl aliquot of each amplification product was electrophoresed on a 0.7% agarose gel in 1× TAE buffer at 50 V for 45 min, stained with ethidium bromide, and the PCR products were visualised with a UV transilluminator. PCR products were purified using Quick PCR purification column (Promega, Madison, WI, USA). Purified PCR products were sequenced with automated DNA sequencer with specific primers using the facility at Macrogen Inc. (Seoul, Korea). The 16S rRNA sequences were subjected to BLAST search from the NCBI database for bacterial strain identification. The reference sequences required for comparison were downloaded from the European Molecular Biology Laboratory (EMBL) database available on the site http://www.ncbi.nlm.nih.gov/GenBank. Sequences of 16S rRNA were aligned by the aid of multiple sequence alignment program CLUSTAL V (Higgins et al. 1992). The aligned sequences were then checked for gaps manually, arranged in a block of 600 bp in each row and saved as molecular evolutionary genetics analysis (MEGA) format in software MEGA v3.0. The pairwise evolutionary distances were computed with the help of Kimura 2-parameter (Kimura 1980). To obtain the confidence values, the original data set was resampled 1,000 times using the bootstrap analysis method. The bootstrapped data set was used directly for constructing the phylogenetic tree by the MEGA v3.0 program for calculating the multiple distance matrixes. The multiple distance matrix obtained was then used to construct phylogenetic trees using neighbour-joining (NJ) method (Saitou and Nei 1987). All these analyses were performed with the aid of MEGA v3.0 (Kumar et al. 2004). The nucleotide sequences of 16S rRNA were deposited in GenBank with accession numbers.
Results
Isolation and screening of phosphate solubilizing bacteria
Of the 80 fluorescent pseudomonad strains, 3 strains (BFPB9, FP12 and FP13) have been identified as phosphate solubilizers based on their ability to solubilize tri-calcium phosphate Ca3(PO4)2 by the formation of visible dissolution halos on Pikovskaya’s agar (Fig. 1; Table 2).
Phosphate solubilization and other traits of strain BFPB9. a Phosphate solubilization on Pikovskaya’s agar medium, b proteolytic activity on skim milk agar, c cellulase production on M9 medium agar amended with cellulose (10 g l−1) yeast extract (1.2 g l−1) and congo red (0.02%), d production of HCN on KB agar supplemented with glycine (4.4 g l−1) as indicated by the discoloration of the filter paper when incubated with picric acid (0.5%) and sodium carbonate (2%)
Time courses of growth and estimation of soluble phosphate
The liberation of soluble phosphate after 10 days was estimated to be 33 μg ml−1 for strain BFPB9, 74 μg ml−1 for strain FP12 and 63 μg ml−1 for strain FP13 (Table 3). The initial pH of the medium was 7.0. Due to the microbial production of organic acids, the decrease of pH in the culture medium from 6.7 to 5.9 by BFPB9, from 6.5 to 5.0 by FP12 and from 6.6 to 5.3 by FP13 was observed (Table 3).
Determination of siderophore, indole-3-acetic acid (IAA), protease and cellulase
All strains tested positive for the production of siderophore, IAA and protease. Strain BFPB9 also produced cellulase and HCN (Fig. 1; Table 2).
Test for antagonism
All three phosphate solubilizing strains showed a broad-spectrum antifungal activity against phytopathogenic fungi used in the study. Strains induced growth-free inhibition zones (diameter) ranging from 10 to 36 mm towards phytopathogenic fungi (Table 4).
Detection of antibiotic genes by PCR and production of antifungal metabolites
When genomic DNA was used as template, reference strains P. fluorescens Pf 5 and P. fluorescens CHAO showed the amplification of DAPG (745 bp), PRN (786 bp) and PLT (779 bp) genes. Similarly, reference strains P. fluorescens 2–79 and P. aeruginosa amplified PCA (1,100 bp) and PCN (2,000 bp) genes, respectively. Reference strain P. aeruginosa PAO1 also amplified PCN as expected. The negative control strain P. stutzeri MTCC 863 did not amplify any genes as expected. Though all the three test strains (BFPB9, FP12, FP13) showed antifungal activity against phytopathogenic fungi they did not show the presence of DAPG, PRN, PLT, PCA and PCN genes when tested in PCR using the gene-specific primers. Strain BFPB9 showed the presence hcnBC gene as indicated in the PCR (587 bp) (Table 5). Consequently, when the strains were tested for the production of antifungal metabolites in the fermentation broth, the ethyl acetate extracts did not show antifungal activity. Subsequently, the absence of known antifungal metabolites such as DAPG, PCA, PCN, PRN and PLT was confirmed by HPLC.
Production of hydrogen cyanide (HCN)
Of three strains, BFBP9 showed the production of HCN as indicated by the discoloration of the filter paper from orange to brown when incubated with picric acid (0.5%) and sodium carbonate (2%) (Fig. 1).
16S rRNA gene amplification, sequencing and phylogenetic tree analysis
The 16S rRNA gene amplicons (1.5 Kb) were amplified using universal primers, fD1 and rP2 and sequenced using the facility at Macrogen (Seoul, Korea). The sequences of the strains BFPB9, FP12 and FP13 were deposited with accession number EF600807, DQ201403 and DQ201404, respectively in NCBI GenBank database. The 16S rRNA nucleotide sequence and phylogenetic analysis revealed the identification of BFPB9 as Pseudomonas aeruginosa (99% similarity), FP12 as P. plecoglossicida (99% similarity) and FP13 as P. mosselii (99% similarity) (Fig. 2).
Phylogenetic tree analysis of phosphate solubilizing strains, BFPB9, FP12 and FP13 based on the nucleotide sequence of 16S rRNA gene. The branching pattern was generated by the neighbour-joining (NJ) method. Bootstrap probability values are indicated at branch-points (tree re-sampled for 1,000 times). Accession numbers are indicated in parentheses
Discussion
Role of fluorescent pseudomonads in agriculture has been a matter of interest due to their abundant population in plant rhizosphere and their innate biocontrol properties and plant growth promoting abilities. In the present investigation, new phosphate solubilizing strains of fluorescent pseudomonads have been reported and their functional characteristics have been determined. The 16S rRNA gene characterization and subsequent phylogenetic tree analysis confirmed the identification of phosphate solubilizing strains as Pseudomonas aeruginosa (BFPB9), P. plecoglossicida (FP12) and P. mosselii (FP13).
Plant growth is often limited by insufficient phosphate availability. The low solubility of common phosphates such as Ca3(PO4)2, hydroxyapatite and aluminium phosphate cause low phosphate availability in agricultural soil. Several species of fluorescent pseudomonads such as P. fluorescens NJ101 (Bano and Musarrat 2004), P. fluorescens EM85 (Dey et al. 2004), P. aeruginosa (Musarrat et al. 2000), Pseudomonas spp. (Lehinos and Vacek 1994; Lehinos 1994), P. chlororaphis, P. savastanoi, P. pickettii (Cattelan et al. 1999), P. lutea OK2 (Peix et al. 2004), P. rhizophaerae LMG 21640, P. graminis DSM11363 (Peix et al. 2003), P. striata (Gaind and Gaur 2002) and P. corrugata (Pandey and Palni 1998) have been reported as phosphate solubilizers. In the present investigation, fluorescent pseudomonad species such as P. aeruginosa, P. plecoglossicida, P. mosselii have been reported as phosphate solubilizers. A significant decline in the pH of the culture medium by strains reported in this study was observed during mineral phosphate solubilization, which suggested the microbial production of organic acids as reported earlier (Illmer and Schinner 1995; Chen et al. 2006; Pandey et al. 2006). Although phosphate solubilization is not necessarily correlated with acidity, from the data presented in this study, relationship could be ascertained between the acidity of medium and the release of soluble phosphates.
Production of phytohormone, IAA by all the strains reported in this study was observed. IAA is known to have dual role in influencing plant growth, by involving in the biocontrol together with glutathione-s-transferases in defence-related plant reactions and inhibits the germination of spore and growth of mycelium of different pathogenic fungi. Indole-3-ethanol, the IAA analogue is also known to exhibit antifungal activity (Brown and Hamilton 1993). Siderophores are low-molecular weight, iron-chelating ligands synthesised by microbes. Siderophores helps a particular microorganism to compete against fungal pathogens for available iron and the role of siderophores in control of diseases has been well documented (Baker et al. 1986). Mycelial growth suppression and inhibition of spore germination were the primary effects of antagonistic strains. All three phosphate solubilizing strains reported in this study exhibited a broad-spectrum antifungal activity against major phytopathogenic fungi that attack important agricultural crops such as rice, groundnut, tobacco, tea, sugarcane, chilli, mango, banana and cotton. PCR and HPLC analyses revealed the absence of antibiotic genes or metabolites such as DAPG, PCA, PCN, PRN and PLT in all three strains. However, the antifungal potential of strains, FP12 and FP13 may be due to the production of protease, IAA and siderophore. In addition to the production of protease, IAA and siderophore, strain BFPB9 also showed the presence of hcnBC genes and the production of HCN. Microbial production of HCN has been reported as an important antifungal trait to control root infecting fungi (Ramette et al. 2003). Strain BFPB9 also exhibited the production of cellulase. Agricultural crop residues applied as cellulosic biomass (cellulose and hemicellulose) contain 55–75% carbohydrates (Mosier et al. 2005). It was reported that phosphate solubilizing bacteria with cellulolytic activity enhanced the mineralization and decomposition of crop residues (Hameeda et al. 2006). Due to the potential of solubilizing the mineral phosphates, production of phytohormones and broad-spectrum antifungal activity against phytopathogenic fungi strains BFPB9, FP12 and FP13 reported in this study may be considered as inoculants for soil fertility, plant growth and plant protection.
References
Alexander DB, Zuberer DA (1991) Use of chrome azurol S reagents to evaluate siderophore production by rhizosphere bacteria. Biol Fertil Soils 12:39–45. doi:10.1007/BF00369386
Ayyadurai N, Ravindra Naik P, Sakthivel N (2007) Functional characterization of antagonistic fluorescent pseudomonas associated with rhizospheric soil of rice (Oryza sativa L.). J Microbiol Biotechnol 17:919–927
Baker R, Elad Y, Sneh B (1986) Physical, biological and host factors in iron competition in soils. In: Swinburne TR (ed) Iron siderophores and plant diseases. Plenum Press, New York, pp 77–84
Bano N, Musarrat J (2003) Characterization of a new Pseudomonas aeruginosa strain NJ-15 as a potential biocontrol agent. Curr Microbiol 46:324–328. doi:10.1007/s00284-002-3857-8
Bano N, Musarrat J (2004) Characterization of a novel carbofuran degrading Pseudomonas sp. with collateral biocontrol and plant growth promoting potential. FEMS Microbiol Lett 231:13–17. doi:10.1016/S0378-1097(03)00894-2
Bric M, John M, Bostock R, Silverstone SE (1991) Rapid in situ assay for indoleacetic acid production by bacteria immobilized on a nitrocellulose membrane. Appl Environ Microbiol 57:535–538
Brown AE, Hamilton JTG (1993) Indole-3-ethanol produced by Zygorrhynchusmoeller, and indole-3-acetic acid analogue with antifungal activity. Mycol Res 96:71–74
Cattelan AJ, Hartel PG, Furhmann FF (1999) Screening for plant growth promoting rhizobacteria to promote early soybean growth. Soil Sci Soc Am J 63:1670–1680
Chen YP, Rekha PD, Arun AB, Shen FT, Lai WA, Young CC (2006) Phosphate solubilizing bacteria from subtropical soil and their tri-calcium phosphate solubilizing abilities. Appl Soil Ecol 34:33–41. doi:10.1016/j.apsoil.2005.12.002
de Souza JT, Raaijmakers JM (2003) Polymorphisms within the PrnD and PltC genes from pyrrolnitrin and pyoluteorin-producing Pseudomonas and Burkholderia spp. FEMS Microbiol Ecol 43:21–34. doi:10.1111/j.1574-6941.2003.tb01042.x
Dey R, Pal KK, Bhatt DM, Chauha SM (2004) Growth promotion and yield enhancement of peanut (Arachis hypogaea L.) by application of plant growth-promoting rhizobacteria. 159:371–394
Gaind S, Gaur AC (2002) Impact of fly ash and phosphate solubilising bacteria on soybean productivity. Bioresour Technol 58:313–315. doi:10.1016/S0960-8524(02)00088-3
Glick BR (1995) The enhancement of plant growth by free living bacteria. Can J Microbiol 41:109–117
Gordon SA, Weber RP (1951) Colorimetric estimation of indoleacetic acid. Plant Physiol 26:192–195
Gulati A, Rahli P, Vyas Pratibha (2008) Characterization of phosphate solubilizing fluorescent pseudomonads from the rhizosphere of sea buckthorn growing in the cold deserts of Himalayas. Curr Microbiol 56:73–79. doi:10.1007/s00284-007-9042-3
Gurusiddaiah S, Weller MD, Sarkar A, Cook JR (1986) Characterization of an antibiotic produced by a strain of Pseudomonas fluorescens inhibitory to Gaeumannomyces graminis var. tritici and Pythium spp. Antimicrob Agents Chemother 29:488–495
Hameeda B, Harish Kumar Reddy Y, Rupela OP, Kumar GN, Reddy Gopal (2006) Effect of carbon substrates on rock phosphate solubilization by bacteria from composts and macrofauna. Curr Microbiol 53:298–302. doi:10.1007/s00284-006-0004-y
Higgins DG, Bleashy AT, Fuchs R (1992) Clustal V: improved software for multiple sequence alignment. Comput Appl Biosci 8:189–191
Homma Y, Suzui T (1989) Role of antibiotic production in suppression of radish damping-off by seed bacterization with Pseudomonas cepacia. Ann Phytopathol Soc Jpn 55:643–652
Illmer P, Schinner F (1995) Solubilization of inorganic calcium phosphates-solubilization mechanisms. Soil Biol Biochem 3:257–263. doi:10.1016/0038-0717(94)00190-C
Kapoor KK, Mishra MM, Kuhkreja K (1989) Phosphate solubilization by soil microoraganisms – a review. Indian J Microbiol 29:119–127
Kim HY, Schlictman D, Shankar S, Xie Z, Chakrabarty MA, Kornberg A (1998) Alginate, inorganic polyphosphate, GTP and ppGpp synthesis co-regulated in Pseudomonas aeruginosa: implications for stationary phase survival and synthesis of RNA/DNA precursors. Mol Microbiol 27:717–725. doi:10.1046/j.1365-2958.1998.00702.x
Kimura M (1980) A simple method for estimating evolutionary rates of base substitutions through comparative studies of nucleotide sequences. J Mol Evol 16:111–120. doi:10.1007/BF01731581
King EO, Ward MK, Raney DE (1954) Two simple media for demonstration of pyocyanin and fluorescein. J Lab Clin Med 44:301–307
Kraus J, Loper EJ (1995) Characterization of a genomic region required for production of the antibiotic pyoluterin by the biological control agent Pseudomonas fluorescens Pf5. Appl Environ Microbiol 61:849–854
Kumar S, Tamura K, Nei M (2004) MEGA3: integrated software for molecular evolutionary genetics analysis and sequence alignment. Brief Bioinform 5:150–163. doi:10.1093/bib/5.2.150
Lehinos V (1994) Effects of pH and glucose on auxin production of phosphate-solubilizing rhizobacteria in vitro. Microbiol Res 149:135–138
Lehinos V, Vacek O (1994) Biosynthesis of auxin by phosphate-solubilizing rhizobacteria from wheat (Triticum aestivum) and rye (Secale cereale). Microbiol Res 149:31–35
Martinez Noel GMA, Madrid EA, Botín R, Lamattina L (2001) Indoleacetic acid attenuates disease severity in potato-Phytophthora infestans interaction and inhibits the pathogen growth in vitro. Plant Physiol Biochem 39:815–823. doi:10.1016/S0981-9428(01)01298-0
Mavrodi DV, Bonsall RF, Delaney SM, Soule MJ, Phillips G, Thomashow LS (2001a) Functional analysis of genes for biosynthesis of pyocyanin and phenazine-1-carboxamide from Pseudomonas aeruginosa PAO1. J Bacteriol 183:6454–6465. doi:10.1128/JB.183.21.6454-6465.2001
Mavrodi OV, Gardener BBM, Mavrodi DV, Bonsall RF, Weller DM, Thomashow LS (2001b) Genetic diversity of phlD from 2,4-diacetylphloroglucinol-producing fluorescent Pseudomonas spp. Phytopathology 91:35–43. doi:10.1094/PHYTO.2001.91.1.35
Mosier N, Wyman C, Dale B, Elander R, Lee YY, Holtzapple M, Ladisch M (2005) Features of promising technologies for pre-treatment of lignocellulosic biomass. Bioresour Technol 96:673–686. doi:10.1016/j.biortech.2004.06.025
Musarrat J, Bano N, Rao RAK (2000) Isolation and characterization of 2, 4-dichlorophenoxyacetic acid acid-catabolizing bacteria and their biodegradation efficiency in soil. World J Microbiol Biotechnol 16:495–497. doi:10.1023/A:1008945720327
Nielsen TH, Christophersen C, Anthoni U, Sorensen J (1999) Viscosinamide, a new cyclic depsipeptide with surfactant and antifungal properties produced by Pseudomonas fluorescens DR54. J Appl Microbiol 86:80–90. doi:10.1046/j.1365-2672.1999.00798.x
Nielsen TH, Thrane C, Christophersen C, Anthoni U, Sorensen J (2000) Structure, production characteristics and fungal antagonism of tensin-a new antifungal cyclic lipopeptide from Pseudomonas fluorescens strain 96.578. J Appl Microbiol 89:992–1001. doi:10.1046/j.1365-2672.2000.01201.x
O’Sullivan DJ, O’Gara F (1992) Traits of fluorescent Pseudomonas sp. involved in suppression of plant root pathogens. Microbiol Rev 56:662–676
Pandey A, Palni LMS (1998) Isolation of Pseudomonas corrugate from Sikkim Himalaya. World J Microbiol Biotechnol 14:411–413. doi:10.1023/A:1008825514148
Pandey A, Trivedi P, Kumar B, Palni LMS (2006) Characterization of a phosphate solubilizing and antagonistic strain of Pseudomonas putida (BO) isolated from a sub-alpine location in the Indian central Himalaya. Curr Microbiol 53:102–107. doi:10.1007/s00284-006-4590-5
Peix A, Rivas R, Mateos PF, Martinez-Molina E, Rodriguez-Barrueco C, Velazquez E (2003) Pseudomonas rhizosphaerae sp. nov., a novel species that actively solubilizes phosphate in vitro. Int J Syst Evol Microbiol 53:2067–2072. doi:10.1099/ijs.0.02703-0
Peix A, Rivas R, Santa-Regina I, Mateos PF, Martinez-Molina E, Rodriguez-Barrueco C, Velazquez E (2004) Pseudomonas lutea sp. nov., a novel phosphate-solubilizing bacterium isolated from the rhizosphere of grasses. Int J Syst Evol Microbiol 54:847–850. doi:10.1099/ijs.0.02966-0
Pfender WF, Kraus J, Loper EJ (1993) A genomic region from Pseudomonas fluorescens Pf-5 required for pyrrolnitrin production and inhibition of Pyrenophora tritici-repentis in wheat straw. Phytopathology 83:1223–1228. doi:10.1094/Phyto-83-1223
Pierson LS, Thomashow SL (1992) Cloning of heterologous expression of phenazine biosynthesis locus from Pseudomonas aureofaciens. Mol Plant Microbe Interact 53:330–339
Pikovskaya RI (1948) Mobilization of phosphorous in soil in connection with vital activity of some microbial species. Mikrobiologiya 17:363–370
Raaijmakers J, Weller DM, Thomashow LS (1997) Frequency of antibiotic producing Pseudomonas spp. in natural environments. Appl Environ Microbiol 63:881–887
Ramette A, Frapolli M, Defago G, Monenne Y (2003) Phylogeny of HCN synthase-encoding hcnBC genes in biocontrol fluorescent pseudomonas and its relationship with host plant species and HCN synthesis ability. Mol Plant Microbe Interact 16:525–535. doi:10.1094/MPMI.2003.16.6.525
Richardson AE (2001) Prospects for using soil microorganisms to improve the acquisition of phosphorus by plants. Aust J Plant Physiol 28:8797–8906
Rodriguez H, Fraga R (1999) Phosphate solubilizing bacteria and their role in plant growth promotion. Biotechnol Adv 17:319–339. doi:10.1016/S0734-9750(99)00014-2
Saitou N, Nei M (1987) The neighbor-joining method: a new method for reconstructing phylogenetic trees. Mol Biol Evol 4:406–425
Sakthivel N, Gnanamanickam SS (1987) Evaluation of Pseudomonas fluorescens for suppression of sheath rot disease and for enhancement of grain yields in rice (Oryza sativa L.). Appl Environ Microbiol 53:2056–2059
Sakthivel N, Gnanamanickam SS (1989) Incidence of different biovars of Pseudomonas fluorescens in flooded rice rhizospheres in India. Agric Ecosyst Environ 25:287–298. doi:10.1016/0167-8809(89)90126-6
Sakthivel N, Mortensen NC, Mathur BS (2001) Detection of Xanthomonas oryzae pv. oryzae in artificially inoculated and naturally infected rice seeds and plants by molecular techniques. Appl Microbiol Biotechnol 56:435–441. doi:10.1007/s002530100641
Smibert RM, Krieg NR (1994) Phenotypic characterization. In: Gerhardt P, Murray RGE, Wood WA, Krieg NR (eds) Methods for general and molecular bacteriology. American Society of Microbiology, Washington, DC, pp 607–654
Sorensen D, Nielsen HT, Christophersen C, Sorensen J, Gajhede M (2001) Cyclic lipoundecapeptide amphisin from Pseudomonas sp. strain DSS73. Acta Crystallogr Sect Crystallogr Struct Commun 57:1123–1124. doi:10.1107/S0108270101010782
Sunish Kumar R, Ayyadurai N, Pandiaraja P, Reddy VA, Venkateswarlu Y, Prakash O, Sakthivel N (2005) Characterization of antifungal metabolite produced by a new strain Pseudomonas aeruginosa PUPa3 that exhibits broad-spectrum antifungal activity and biofertilizing traits. J Appl Microbiol 98:145–154. doi:10.1111/j.1365-2672.2004.02435.x
Sutra L, Rojas MA, de los Rios GEJ, Saux Fischer-Le M, Jimenez P, Reche P, Bonneau S, Mathieu-Daude F, McClelland M (2001) Erwinia toletana sp. nov., associated with Pseudomonas savastanoi-induced tree knots. Int J Syst Evol Microbiol 54:2217–2222
Vassilev N, Vassileva M, Nikolaeva I (2006) Simultaneous P-solubilizing and biocontrol activity of microorganisms. Appl Microbiol Biotechnol 71:137–144. doi:10.1007/s00253-006-0380-z
Weisburg WG, Barns SM, Lane DJ (1991) 16S ribosomal DNA amplification for phylogenetic study. J Bacteriol 173:697–703
Acknowledgments
We thank the Department of Biotechnology, Ministry of Science and Technology, Government of India for financial assistance.
Author information
Authors and Affiliations
Corresponding author
Rights and permissions
About this article
Cite this article
Jha, B.K., Gandhi Pragash, M., Cletus, J. et al. Simultaneous phosphate solubilization potential and antifungal activity of new fluorescent pseudomonad strains, Pseudomonas aeruginosa, P. plecoglossicida and P. mosselii . World J Microbiol Biotechnol 25, 573–581 (2009). https://doi.org/10.1007/s11274-008-9925-x
Received:
Accepted:
Published:
Issue Date:
DOI: https://doi.org/10.1007/s11274-008-9925-x